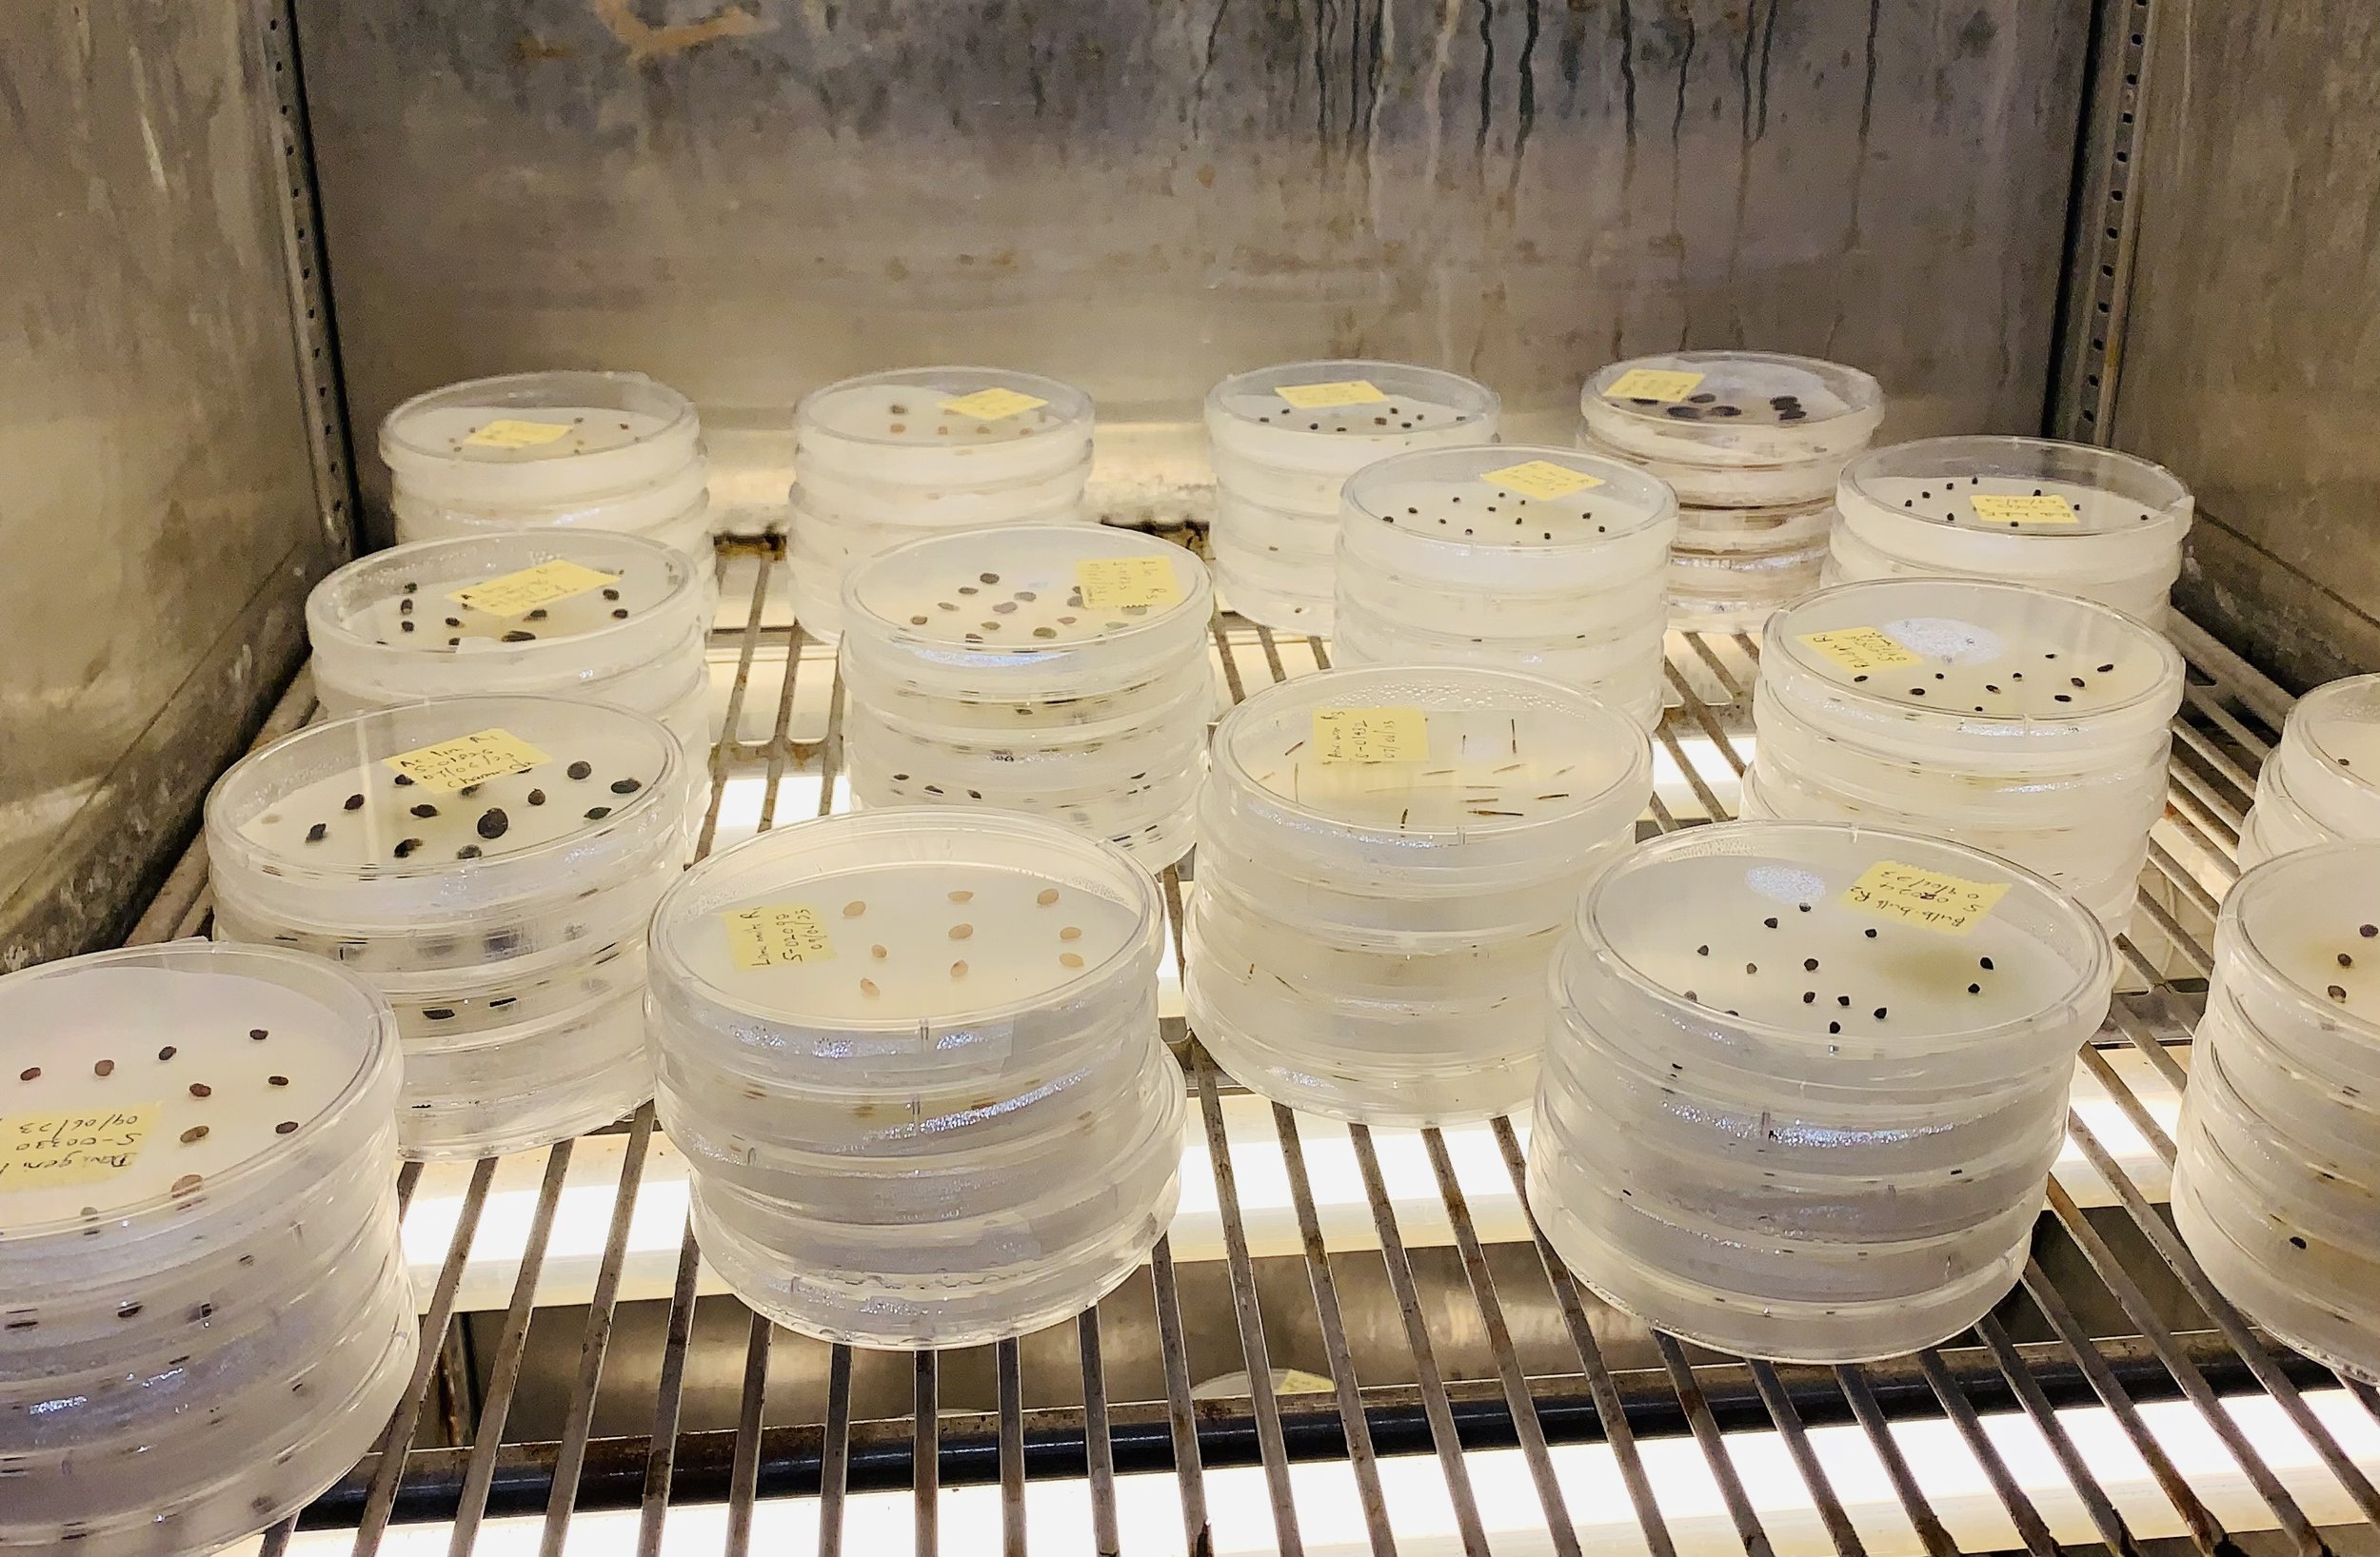

Projects
Strengthening Aboriginal Knowledge and Practices

This project collaborates with D’harawal Knowledge Holders to explore and showcase Indigenous Knowledges, colonial archives, and flora connections in the Cumberland Plains.

This project assesses urbanisation’s impact on Western Sydney’s platypus populations, integrating Aboriginal knowledge and ecological research to guide conservation efforts.

Reclaiming Aboriginal edible root grounds on the Cumberland Plain
This project explores historical edible root species on the Cumberland Plain, integrating Indigenous knowledge and scientific research to guide biocultural restoration.
Prioritising Sites for Shared Cultural, Conservation and Restoration Values

Prioritisation of Sites Through Shared Social, Cultural and Conservation Values
This project examines the contrast between Indigenous and Western views of human-nature relationships, advocating for a whole-of-society approach to conservation in Western Sydney.

(M)any Takers? Uptake Determinism in Strategic Conservation Planning
This project explores adaptive management strategies to improve landholder participation in conservation programs, addressing enrolment uncertainty and enhancing ecological outcomes.

Relational Pathways to Mainstreaming Social and Cultural Values into Private Land Conservation
This project explores how social and cultural values influence private land conservation, aiming to improve landscape connectivity and public engagement in Western Sydney.
Enhancing the Health and Resilience of Ecosystems

Community Appreciation of Biodiversity (CAB) Survey for the Cumberland Plain
This project uses the CAB survey to assess attitudes toward biodiversity in Western Sydney, aiming to improve community engagement in conservation efforts.

Soil biodiversity and functions in the Cumberland Plain Woodland
This project surveys soils across 50 Cumberland Plain Woodland sites to create baseline data linking soil attributes to ecosystem health and vegetation integrity.

This project examines the impact of soil degradation on native plant growth in Cumberland Plain Woodland, focusing on seed germination and growth in degraded and pristine sites.

This project examines the impact of soil pollution and extreme climate events on plant diversity and ecosystem recovery in Cumberland Plain Woodland.

This project investigates how plant diversity and soil biology affect the resilience and resistance of critical soil processes to future climate events in Cumberland Plain Woodland.

This PhD project aims to guide Cumberland Plain conservation by consolidating data, mapping vegetation, and assessing biodiversity for restoration planning.

Climate change effects on plant traits (stress, flammability) estimated by leaf spectra
This study investigates how climate change affects plant stress, flammability, and spectral attributes in Cumberland Plain native species.

Is resilience to weed invasion related to plant richness in Cumberland Plain Woodlands?
This project tests whether lower strata diversity enhances resilience to weed invasion in Cumberland Plain Woodlands.
Improving Management of Climate Change Risks

Too Hot To Handle? Testing critical thresholds of climate sensitivity for Cumberland Plains flora
This project assesses climate sensitivity and resilience of 32 Cumberland Plain species to inform targeted restoration interventions.

This project characterises germination niches of Cumberland Plain species to predict climate change impacts on recruitment and community composition.

Cumberland Plain Woodland research and monitoring plot network
This project establishes a network of sentinel sites to monitor and understand ecosystem function and biodiversity in Cumberland Plain Woodlands.

Appin reconstruction site soil assessment and report to NSW DPI
In March 2024, soil samples from the Appin reconstruction site were analysed, providing a baseline for restoration planning and monitoring.

This research examines the impact of topsoil removal depth on seed bank emergence and native plant recovery in degraded Cumberland Plain Woodlands.

Exploring aboveground and belowground linkages
This study explores how above- and belowground processes influence native understorey establishment in degraded Cumberland Plain Woodlands.

Evaluating direct koala benefits of early-stage habitat restoration actions
This project evaluates revegetation effectiveness for koala habitat, providing insights into restoration practices and habitat usefulness over time.

This project examines the effects of elevated CO₂ and soil phosphorus on ground cover dynamics in the EucFACE experiment, providing insights into ecosystem responses to climate change and extreme weather events.

This study examines how habitat fragmentation, altered fire regimes, and climate change impact leaf traits in Cumberland Plain species.

Habitat homes as fertile islands
This study examines how habitat homes influence soil function and support restoration efforts for small mammals in Western Sydney Parklands.

Restoring Ecosystems under Climate Change (RE-Clim)
The RE-Clim project tests climate-adjusted provenancing for Cumberland Plain Woodlands species to enhance climate resilience in restoration.
Seedling establishment in response to warming and reduced rainfall under climate change
This project tests how warming and reduced rainfall impact seedling establishment and evaluates sourcing seeds from diverse climates.

Effectiveness of woodland restoration interventions
This meta-analysis evaluates restoration interventions in Australian woodlands, identifying effective strategies for improving plant and soil health.

This study explores how aboveground and belowground factors influence plant species establishment across degradation gradients in Sydney’s threatened communities.

Exploring the Impact of Soil Depth and Planting Species Diversity on Early-Stage Restoration
This study investigates the effects of soil layer composition and planting diversity on early restoration success in Cumberland Plain Woodlands.

Long-term successional trajectories of restoration plantings for Cumberland Plain Woodland
This project uses a 30-year monitoring dataset to improve knowledge on successful restoration outcomes and inform future conservation planning.

This study examines how forest fragmentation and seasonal shifts affect plant traits in Cumberland Plain's understory and canopy.

This project reconstructs pre-clearance vegetation of the Cumberland Plain, focusing on grassy woodlands and fire dynamics to inform restoration.

This meta-analysis aims to identify species attributes predicting seed germination, emergence, and survival across ecosystems, focusing on climate origin.

This study investigates how regional climate, canopy cover, and leaf litter affect seedling emergence and survival in Cumberland Plain Woodlands.
Identifying Cost-Effective Management Practices to Enhance Biodiversity

This project assesses the availability of tree hollows that provide critical habitat for hollow-dependent wildlife in remnant Cumberland Plain woodlands. The research will inform management approaches to support arboreal vertebrates and improve woodland habitat quality.

This study explores the relationship between soil properties and plant composition in degraded Cumberland Plain Woodlands, aiming to guide restoration strategies.

This study explores how topsoil removal, plant diversity, and water availability affect native understorey establishment and control invasions.

This project investigates how tree diversity, canopy cover and woodland structure influence native herb communities in threatened grassy woodlands. Findings will help guide restoration and conservation management across the Cumberland Plain.

Mapping incursions of Phytophthora and other oomycete pathogens across the Cumberland Plain
This project investigates the distribution and impact of Phytophthora cinnamomi in the Cumberland Plain using metabarcoding, providing insights to inform management strategies for controlling pathogen spread and supporting ecosystem resilience.